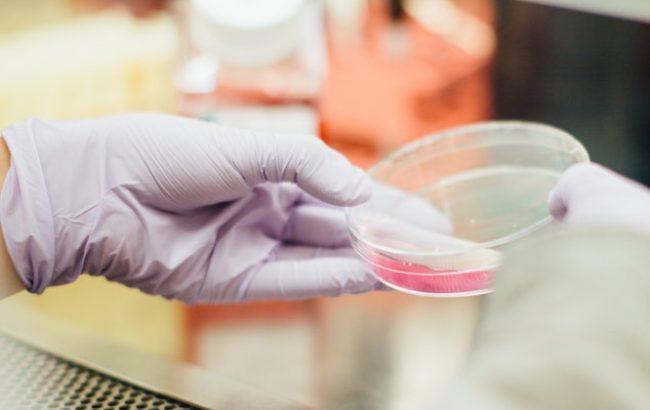
У Дніпрі СБУ затримала виробників наркотиків

У Дніпрі СБУ затримала виробників наркотиків
Фото: виготовлення наркотиків (unsplash.com/Drew Hays)
Фото: виготовлення наркотиків (unsplash.com/Drew Hays)
Співробітники Служби безпеки України спільно з поліцією і прокуратурою припинили діяльність організованого наркоугруповання, яке налагодило виробництво метамфетаміну. Про це сьогодні, 30 листопада, повідомив прес-центр СБУ.
"Правоохоронці встановили, що зловмисники створили розгалужену мережу збуту наркотиків на території Одеської, Дніпропетровської, Харківської, Київської та Донецької областей, у тому числі вони постачали метамфетамін бойовикам "ДНР", - йдеться у повідомленні.
Організатором виявився мешканець Донецька. 2015 року ділок на непідконтрольній українській території виготовляв та реалізовував місцевому населенню метамфетамін. Через конфлікт з представниками "МГБ ДНР" щодо розподілу доходу від продажу психотропу він втік з "ДНР" і переїхав до Дніпропетровської області.
Співробітники визначили місце його перебування, розташування підпільної лабораторії і особи спільників.
Трьох членів угруповання затримали у Дніпрі під час збуту чергової партії наркотику. У ході обшуків правоохоронці вилучили підготовлені до продажу розфасовані 150 грамів психотропу, лабораторне обладнання для його виробництва, бойові набої і гранату РГД.
Нагадаємо, 28 листопада в Харківській області у місцевого жителя вилучили зброю та наркотики. Зловмиснику загрожує покарання у вигляді позбавлення волі на строк до 7 років.






